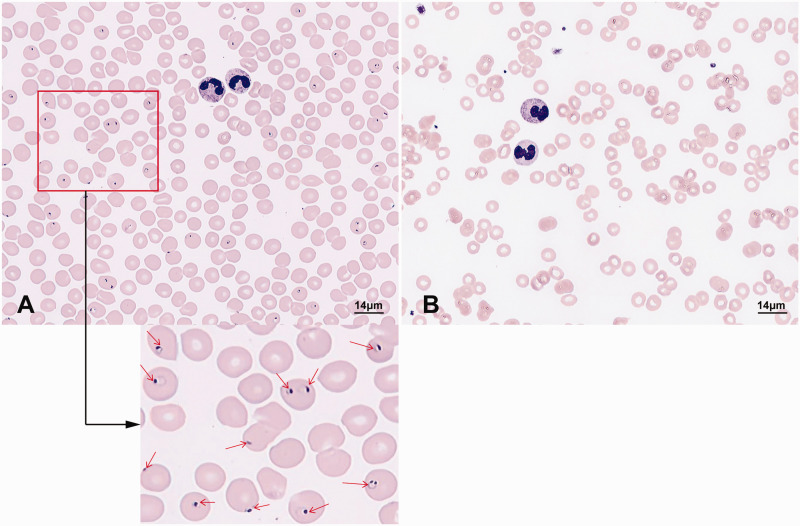

恶性疟原虫疟疾并发急性硬膜下血肿1例。
IF 1.5
4区 医学
Q4 MEDICINE, RESEARCH & EXPERIMENTAL
Journal of International Medical Research
Pub Date : 2025-09-01
Epub Date: 2025-09-03
DOI:10.1177/03000605251372432
引用次数: 0
摘要
本病例详细介绍了一名50多岁、体重90公斤的男性患者,他曾前往非洲布基纳法索旅行约1个月。他在返回中国重庆3天后出现发烧、头痛和全身肌痛。从患者出现症状到诊断为严重恶性疟疾和开始青蒿琥酯治疗的时间间隔为9天。尽管进行了有效的抗恶性疟原虫治疗,但患者最终死于恶性疟原虫感染并发急性硬膜下血肿引起的多器官衰竭。本文章由计算机程序翻译,如有差异,请以英文原文为准。

A fatal case report of Plasmodium falciparum malaria complicated by acute subdural hematoma.
This case details a male patient in his late 50s weighing 90 kg who traveled to Burkina Faso, Africa, for approximately 1 month. He developed fever, headache, and generalized myalgia 3 days after returning to Chongqing, China. The interval from the emergence of the patient's symptoms to the diagnosis of severe falciparum malaria and the commencement of artesunate treatment was 9 days. Despite effective anti-Plasmodium falciparum treatment, the patient ultimately succumbed to multiple organ failure caused by P. falciparum infection complicated by an acute subdural hematoma.
求助全文
通过发布文献求助,成功后即可免费获取论文全文。
去求助
来源期刊
CiteScore
3.20
自引率
0.00%
发文量
555
审稿时长
1 months
期刊介绍:
_Journal of International Medical Research_ is a leading international journal for rapid publication of original medical, pre-clinical and clinical research, reviews, preliminary and pilot studies on a page charge basis.
As a service to authors, every article accepted by peer review will be given a full technical edit to make papers as accessible and readable to the international medical community as rapidly as possible.
Once the technical edit queries have been answered to the satisfaction of the journal, the paper will be published and made available freely to everyone under a creative commons licence.
Symposium proceedings, summaries of presentations or collections of medical, pre-clinical or clinical data on a specific topic are welcome for publication as supplements.
Print ISSN: 0300-0605

 求助内容:
求助内容: 应助结果提醒方式:
应助结果提醒方式:


